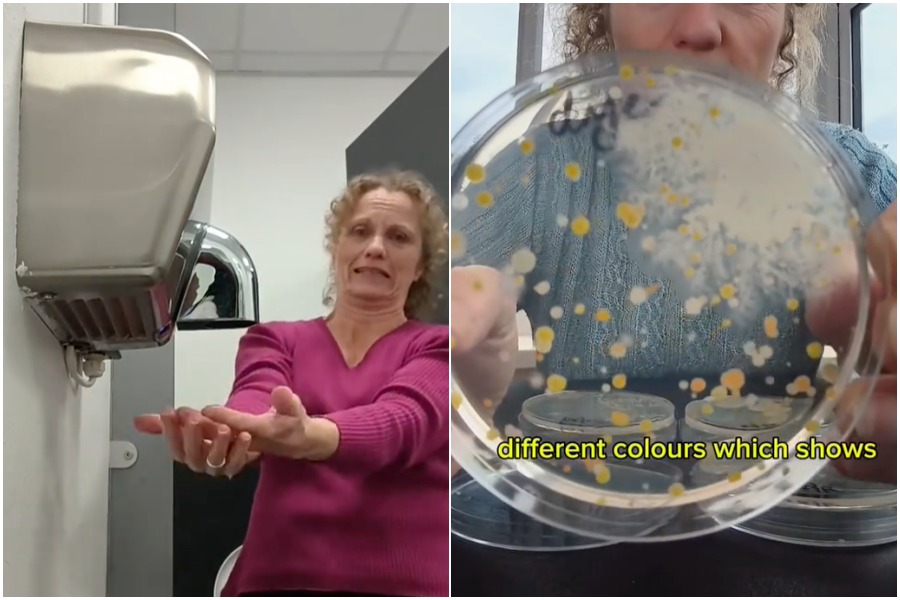
8482017

英国科学家露丝·麦克拉伦(Ruth MacLaren)近日通过一项实验,揭露公共厕所烘手机潜藏的惊人卫生隐患——她发现烘手机吹出的风中竟充满大量细菌与真菌,经过一夜培养后,培养皿上竟长满各种微生物,让她直呼:“这就是我从不用烘手机的原因!”
据《Devon Live》报道,麦克拉伦是英国“德文科学教育计划”(Devon Science)创办人。她日前在TikTok上传实验影片,展示如何将培养皿放在公厕烘手机出风口下方收集空气样本,并准备另一组培养皿在普通空气中挥动作为对照组。
经过一夜培养后,结果令人震惊:来自烘手机的样本上布满形态各异的细菌与真菌,而对照组的培养皿几乎一尘不染。麦克拉伦指出,这显示烘手机在吹干双手时,可能同时将细菌从空气中或机器内部散播到皮肤上。
这段视频迅速走红,短时间内累积超过一千万次观看,引发网民热烈讨论。许多人惊呼再也不敢用烘手机:“我宁愿用衣服擦手,也不要被这些风吹到!”、“我一直怀疑烘手机不卫生,现在终于有证据了。”
不过,也有网友质疑实验对照不严谨,指出麦克拉伦取样的对照组空气来自办公室而非厕所,因此可能影响结果。对此,麦克拉伦也坦言实验存在局限,并承诺将进行进一步测试,比较不同环境下烘手机与空气中微生物含量的差异。
无论如何,这项实验再次引发公众对公共卫生设备的关注,不少人表示今后将更倾向使用纸巾擦手,以避免“风中带菌”的风险。